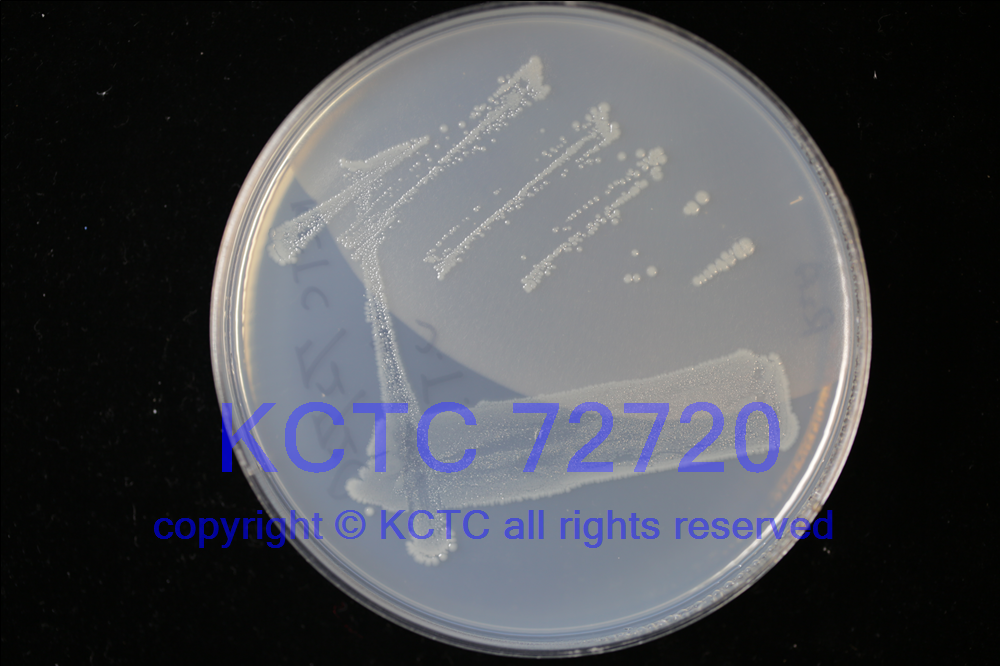

KCTC No. 72720
(KCTC Other No.)
Resource Type Bacteria
Name Caballeronia ginsengisoli
Type Strain Yes
Biosafty Level 1
LMO No
Synonym
Phylum (ex Phylum) Pseudomonadota (Proteobacteria - Betaproteobacteria)
Genome Information
History <- Wan-Taek Im, Hankyoung National Univ.
Source From ginseng cultivating soil, Republic of Korea
Other Collection No. Gsoil 652, KACC [19441], LMG [30326]
Reference
KCTC Media No. KCTC media No. 493 R2A agar medium
Oxygen Requirement Aerobic
Temperature 30 ℃
pH 7
Incubation Time 2-3 d [???? ???? ????? ??, ?? ? ????? ??? ?? ?? ? ??]